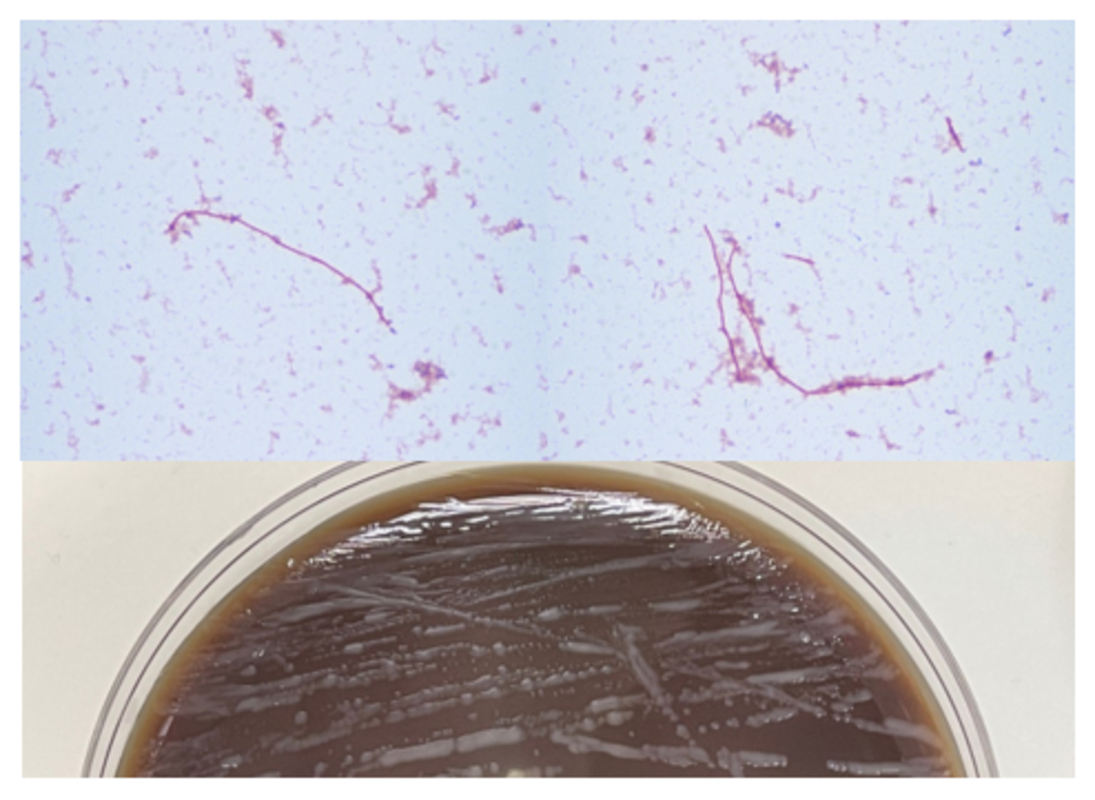

Мужчина 34 лет поступил в отделение неотложной помощи с острой болью в животе, тошнотой, рвотой, постоянной лихорадкой и ознобом.
Физикальное обследование на тот момент соответствовало аппендициту, но визуализация показала нормальный аппендикс. Через три дня после забора крови у пациента был получен положительный результат на грамнегативные, удлиненные, тонкие палочки. По результатам MALDI-TOF было установлено, что это Fusobacterium mortiferum. Был начат прием ампициллина/сульбактама и пациенту назначили амоксициллин/клавулановую кислоту для амбулаторного лечения. Дальнейшее наблюдение за пациентом показало нормальный уровень лейкоцитов и нормальный анализ мочи. Повторные посевы крови были отрицательными.
Окрашивание по Граму, демонстрирующие длинные, тонкие, грамотрицательные палочки (вверху) и рост бактерий на анаэробной среде (внизу) из флакона с положительной культурой крови.
Обсуждение
Fusobacteria - это анаэробные, грамотрицательные, веретенообразные палочки с заостренными концами. Они являются частью флоры верхних дыхательных путей и желудочно-кишечного тракта человека, но могут вызывать заболевания от тонзиллита до септического шока. Fusobacterium nucleatum и necrophorum обычно выделяются при заболеваниях человека, хотя другие виды, такие как Fusobacterium mortiferum, как описано в нашем случае, иногда документируются как вторичная причина септицемии или бактериемии и в редких случаях участвуют в развитии абсцесса щитовидной железы.
F. nucleatum является членом орофарингеальной флоры и неудивительно, что она вовлечена в заболевания десен и пародонта. Она также была описана как наиболее вероятная причина экстраоральных инфекций среди анаэробов полости рта. F. nucleatum обнаруживали в различных фетальных и плацентарных тканях, связанных с неблагоприятными исходами беременности, такими как преэклампсия, хориоамнионит и преждевременный разрыв плодных оболочек.
Недавние исследования показали, что этот вид в изобилии встречается при раке толстой кишки, карциноме пищевода, раке поджелудочной железы и молочной железы. Он ассоциируется с плохим прогнозом при раке толстой кишки, прямой кишки, поджелудочной железы и пищевода, поскольку способствует развитию проопухолевого иммунного микроокружения и снижению количества опухоль-инфильтрирующих лимфоцитов.
Одной из предложенных теорий является участие фактора вирулентности Fap2, который, как было описано, подавляет клиренс опухолевых клеток в клетках колоректального рака. Другим часто выделяемым видом является F. necrophorum, который ассоциируется с орофарингеальной инфекцией с последующим септическим тромбофлебитом внутренней яремной вены с сепсисом и метастатическими поражениями, как правило, легких. Этот синдром известен как болезнь Лемьера, впервые описанная в 1936 году Андре Лемьером.
F. necrophorum обычно вызывает инфекцию у молодых, в остальном здоровых взрослых, в отличие от F. nucleatum , который больше ассоциируется с пожилым возрастом. По данным Afra et al. большинство смертельных случаев было вызвано F. nucleatum в отличие от F. necrophrum. Это может быть связано с сопутствующими заболеваниями у пожилых пациентов с положительными культурами F. nucleatum.
Виды Fusobacterium могут быть идентифицированы с помощью масс-спектрометрии MALDI-TOF. Обычно виды Fusobacterium резистентны к ванкомицину, но чувствительны к колистину и канамицину в тестах идентификации; однако F. nucleatum чувствителен ко всем трем препаратам. F. mortiferum и F. varium растут в присутствии желчи. F. necrophorum показывает положительный тест на индол и отрицательный тест на нитраты. Для дифференциации видов можно использовать секвенирование гена 16S РНК и спейсерной области гена 16S-23S рРНК.
Виды Fusobacterium обычно чувствительны к пенициллину, клиндамицину, метронидазолу и хлорамфениколу и резистентны к макролидам. F. nucleatum и F. necrophorum могут продуцировать бета-лактамазы. В редких случаях при образовании абсцесса необходимо хирургическое вмешательство.
